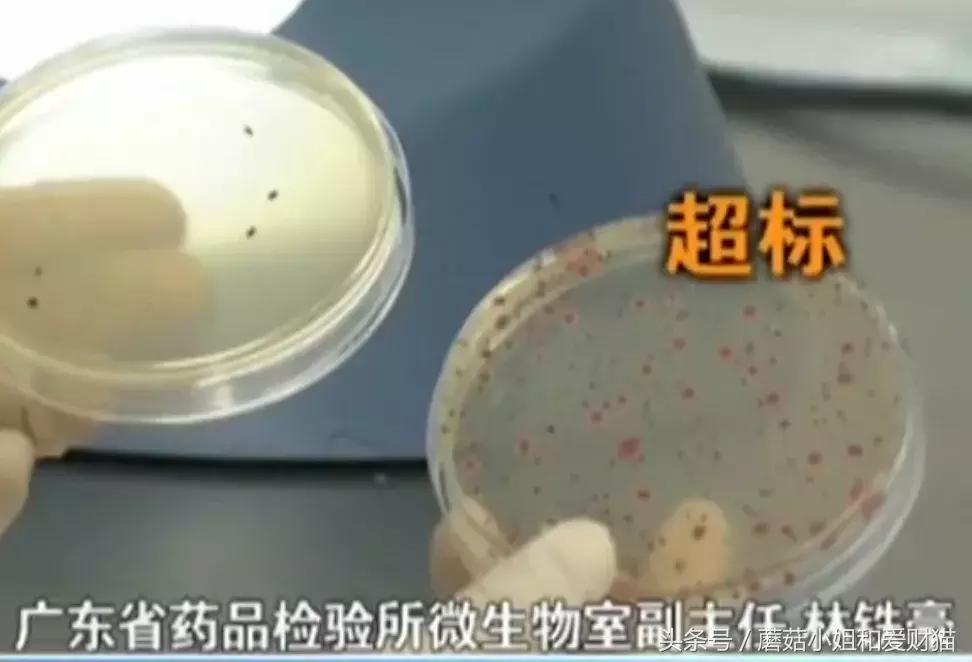
用了就烂脸的面膜,让人用了会烂脸的面膜

微博真是个好东西,明星、网红、还是新闻都逃不过强大的微博热点。我没事儿呢,就是喜欢刷刷微博,前几天看到吴秀波跟女明星的地下情又劈腿,中间还有动手打女人的桥段,真真儿让我吃了一大惊。

央视上报道了国家药品监督管理局对27批次不合格面膜进行的通告。

不知道大家看了视频没?讲真,里面的面膜不少都是微商啊、“三无”之类的品牌,就靠着价钱便宜来占据市场。我们一起扒一扒视频里的产品吧~
概括起来就是两个问题。一个是菌落超标,另一个就是激素的问题啦!
激 素
激素一拿出来有点护肤常识的北鼻就会知道,这玩意儿可不好惹。激素脸最直接表现就是皮肤出现白头和黑头粉刺、炎性丘疹、脓疱、结节和囊肿。还会发红、发痒、甚至流脓水...

看看,激素脸可跟平时小打小闹的过敏完全不一样,看起来更可怕。像这种药物性*疮痤**就是因为间断或者是长时间使用了含有激素的美容化妆品而引起的,已经上升到严重皮肤病的程度!!
这次被点名拎出来的面膜中就有2款是含有激素的,分别是膜法X迹之补养面膜、静距X千颜蜜语桃花净颜靓肤面膜。


以上面膜均被检测出含有糖皮激素。
ps:糖皮激素常用于医用范畴。多用于病情危重抢救,具有抗炎、抗过敏和抗休克等作用。

刚用上这种激素面膜能收缩毛细血管,因此皮肤泛红、过敏的情况就会消失;至于皮肤会变得水润是因为敷上激素面膜后肌肤含水量增加,肌肤摸上去就会变得特别水嫩。

所以很多北鼻就会被它欺骗,开始疯狂喜欢这种面膜,以为它就是皮肤的“救命良药”。
激素虽然具有抗炎性,但同时有个最大的弊病,也是让肌肤变坏的根本原因,它会抑制蛋白的产生!

不仅如此,经常使用激素面膜会让肌肤角质层变薄,令肌肤变得更加敏感;还会使毛细血管扩张,这样皮肤表面就会变红红的。
最可怕的是长期使用激素类产品皮肤自身的代谢能力就会减弱,细胞活性受到抑制后皮肤就会越来越干燥、越来越粗糙...可怕!!

菌落超标
人体自身的皮肤自带菌落(细菌),这对肌肤的正常代谢和酸碱度平衡都是有好处滴。然鹅超标的菌落就另当别论啦!

假如刚好皮肤创口,细菌就会进入到皮肤内形成感染。还会导致皮肤原本正常的菌群失调,从而肌肤屏障受损有、皮肤变得敏感脆弱。

通过化妆品监督抽查的权威机构之一广东省药品检验所特别做的实验就能检测出哪款面膜不合格。为了让我们直观地看出超标面膜和普通面膜的区别,分别采集了合格面膜和不合格面膜后,经过48小时的培养就出现了肉眼可见的菌落形态。
接下来北鼻们一定要睁开眼睛看老师。记住这些比垃圾还脏的面膜,千万别一不小心就踩了雷啊~~
首先就是茜X雨露,他家的旗舰店我之前看了,熊果苷雪颜亮肤隐形面膜评论区满屏的过敏分享不用我多说,你们也明白了吧~

我只能说呵呵!不用你们在那不承认,广东省药品检验所已经检测出熊果苷雪颜亮肤隐形面膜的菌落超标84!!

真的劝北鼻们别买茜X雨露的面膜了,除了熊果苷这款,国家药品监督管理局的通告中还曝光了他家的其他3款产品:洋甘菊舒缓调理面膜、备长炭净颜水润黑金面膜还有沁颜芯鲜润·复活草瞬透沁润补水面膜(都是广州博弈化妆品有限公司),这3款面膜的菌群超标都在26倍以上!
你们真以为这就够了?那可太天真了!X国天使婴儿蚕丝面膜超标1000倍!珀薇·X膜蓝莓嫩肤细致面膜更是超标7200倍!!


在菌群超标的面膜里我竟然发现一大家应该都知道的森田保湿精华水润面膜!这个我之前是用过滴,怪不得用完森田那段时候不太长痘的我都开始爆痘...现在想想真是害怕...
除了以上的面膜,北鼻们看到水盈七子白水分缘面膜、谷幽兰净白面膜、美丽习惯从容美白面膜、玉颜面膜一号和玉颜面膜二号、名蔻玻尿酸水漾透亮双层面膜、若泉水磁场立润保湿蚕丝面膜、纤之恋倍润修护丝滑海藻面膜、纤之恋雪肌亮肤补水海藻面膜、海洋传说补水透白面膜、海洋传说深海鱼油高倍水润面膜这些面膜也要绕开,它们也是菌落超标上的黑名单哦!
假冒产品
在这次不合格面膜的通告中,还有俩面膜X美玻尿酸原液水润赋嫩蚕丝面膜、佐X偌蚂蚁深层润白保湿神仙面膜涉嫌假冒。


很多企业和生产许可证过期了,但证号仍旧是可以查到的。商家虽然艺不高但是人胆大啊,靠着打擦边球,照样生产产品来售卖。这对消费者是特别不负责的!
写了这么多北鼻们应该明白了吧~总体来说就是菌群超标、含有激素、没有品牌的擦边球品牌产品一定不要买!为了方便大家避雷,不合格面膜的汇总表格就给你们啦~

大家购买面膜的时候可一定要擦亮大眼睛呦!